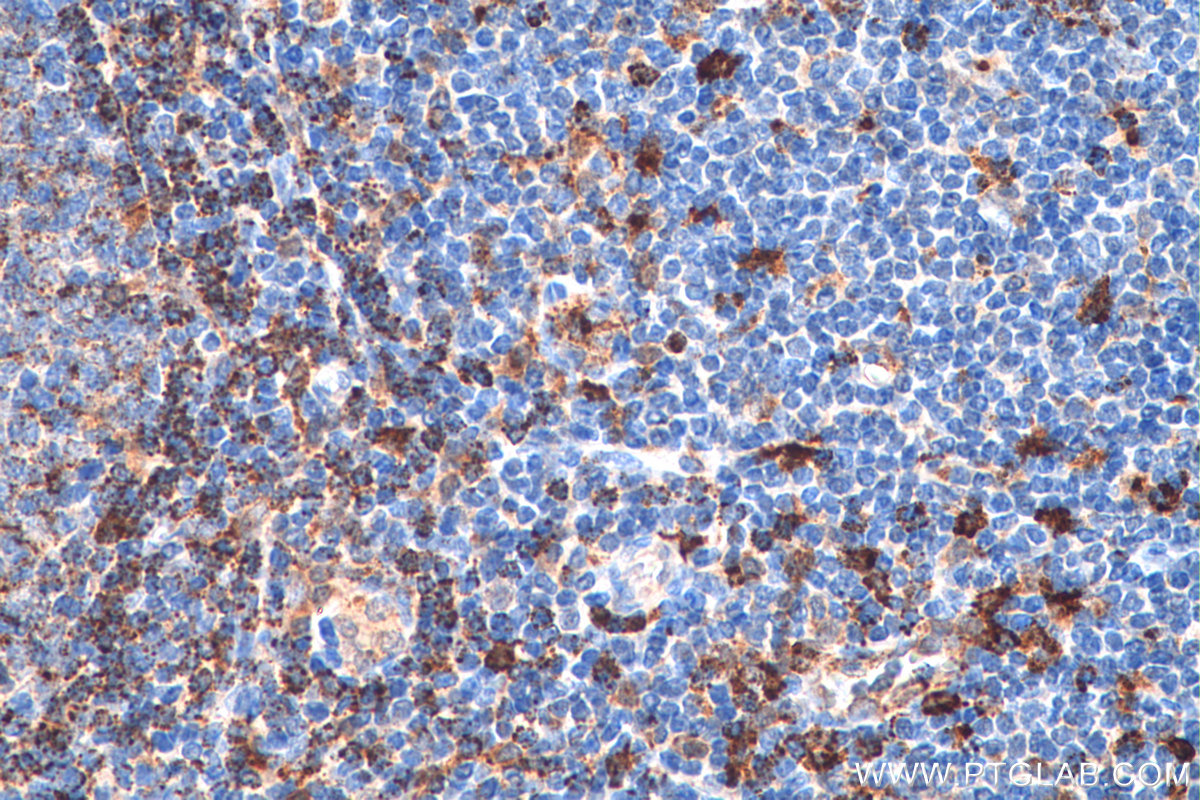

验证数据展示
产品信息
11838-1-PBS targets HLA-DMA in WB, IHC, Indirect ELISA applications and shows reactivity with human, mouse, rat samples.
| 经测试应用 | WB, IHC, Indirect ELISA Application Description |
| 经测试反应性 | human, mouse, rat |
| 免疫原 |
CatNo: Ag2452 Product name: Recombinant human HLA-DMA protein Source: e coli.-derived, PGEX-4T Tag: GST Domain: 21-261 aa of BC026279 Sequence: LPHSWAVPEAPTPMWPDDLQNHTFLHTVYCQDGSPSVGLSEAYDEDQLFFFDFSQNTRVPRLPEFADWAQEQGDAPAILFDKEFCEWMIQQIGPKLDGKIPVSRGFPIAEVFTLKPLEFGKPNTLVCFVSNLFPPMLTVNWQHHSVPVEGFGPTFVSAVDGLSFQAFSYLNFTPEPSDIFSCIVTHEIDRYTAIAYWVPRNALPSDLLENVLCGVAFGLGVLGIIVGIVLIIYFRKPCSGD 种属同源性预测 |
| 宿主/亚型 | Rabbit / IgG |
| 抗体类别 | Polyclonal |
| 产品类型 | Antibody |
| 全称 | major histocompatibility complex, class II, DM alpha |
| 别名 | D6S222E, DMA, DMA protein, DMA protein MHC class II antigen Major histocompatibility complex, class II, DM alpha cDNA FLJ75740, highly similar to Homo sapiens major histocompatibility complex, class II, DM alpha, hCG_2001572 |
| 计算分子量 | 261 aa, 29 kDa |
| 观测分子量 | 55-60 kDa |
| GenBank蛋白编号 | BC026279 |
| 基因名称 | HLA-DMA |
| Gene ID (NCBI) | 3108 |
| RRID | AB_874186 |
| 偶联类型 | Unconjugated |
| 形式 | Liquid |
| 纯化方式 | Antigen affinity purification |
| UNIPROT ID | P28067 |
| 储存缓冲液 | PBS only, pH 7.3. |
| 储存条件 | Store at -80°C. The product is shipped with ice packs. Upon receipt, store it immediately at -80°C |
背景介绍
Human major histocompatibility complex (MHC) antigens, also referred to as human leukocyte antigens (HLA), are encoded by genes located on the short arm of chromosome 6 (6p21.3). There are two classes of HLA antigens: class I (HLA-A, B and C) and class II (HLA-D). The class II molecules are composed of two non-covalently associated alpha and beta chains. HLA-DMA and HLA-DMB form a functional heterodimer that is critical in the pathway of class II antigen presentation. HLA-DM plays a critical role in catalyzing the release of Class II HLA-associated invariant chain-derived peptides (CLIP) from newly synthesized class II HLA molecules and freeing the peptide binding site for acquisition of antigenic peptides. This antibody recognizes the 33kd HLA-DMA and the 50-60kd dimer in Western blotting.